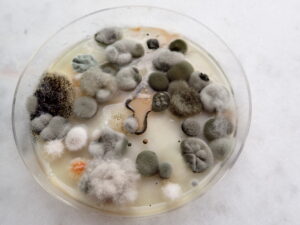
Home mold test kit with mold colonies that I did some analysis of at home.
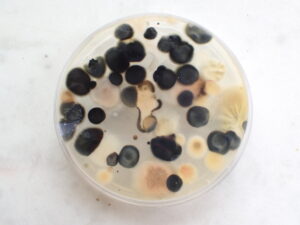
Reverse side of a home mold test kit. I turned it upside down to show what the bottom of the colonies look like.

PETRI DISH HOME MOLD TESTING KITS AND MOLD TESTING COMPANIES
In this article we explain the limitations of home mold test kits. To get a basic idea of how labs identify mold in petri dish test kits see the below photos. For a detailed lab ID send your samples to a lab. And to learn what toxic black mold or Stachybotrys looks like in a petri dish click here.
Do you feel that you have a mold problem? You may believe that you can save money by buying a do it yourself mold test kit. Some people buy these kits to try and avoid hiring mold testing companies. Later, they realize the kits provide more questions than answers. In the long run, these people often still have to hire a mold testing company. These companies provide inspections that give the answers you are looking for.

Home mold test kits. These six petri dishes were used by one of our mold testing customers in West Palm Beach. Five of the six mold test kits have mold growing in them. This is not too unusual.
About Mold Test Kits
If you live anywhere in the USA you can likely find these kits. However it was a laboratory called Pro Lab that was possible the first company to offer these kits.
The home mold testing kit consists of a plastic petri dish containing a mold growth media. The gelatinous growth media is typically MEA (Malt Extract Agar). The media was made by boiling very common seaweed. Simply open the petri dish. Spores will passively settle on the Malt Extract Agar from the air above. Within a few days, mold colonies will start to grow.
What to Look For
Want to know what mold looks like in a petri dish. Typically, after a few days or a week or so you will see black, white, tan, brown, gray, and green mold colonies. Most colonies might appear slightly fuzzy. The mold types in the mold testing kit will usually be mostly Penicillium/Aspergillus-type molds, Cladosporium, Mucor, and a few others. Often smaller colonies of what appear to be smooth shiny or creamy droplets of wax may also appear. These tiny growths may be white, pink, or tan. These tiny growths are likely yeast.
While homeowners are often frightened by the test results, it is completely normal and expected for some mold to grow. Mold grows in almost every sample, even if you do not have a mold problem. This is because all homes have some mold spores in the air. But no home should have actual unusual mold conditions in the form of visible mold growth. no home should have elevated mold spore levels in the air.
You might want to try these test kits if you are curious and want basic information about some of the spores in your air. However, Petri dish mold test kits cannot accurately tell you the number of spores in your air. Or where they likely came from. Therefore, they are popular and interesting, but the helpful information you get from them is very limited.
Images of Mold Growing in Petri Dishes.

Three colonies of Stachybotrys mold in a petri dish. If this is in your sample you almost certainly have water damage. In addition, this slow growing toxin producing mold is often hidden in dark places. It often grows slowly where hidden leaks have occurred un-noticed for long periods of time. The colonies in this photo started out white, next they started to turn black in the centers. Next the black centers will expand to eventually cover the entire colony’s surfaces till the entire colonies are black. If you want to learn more about what Toxic Black mold looks like in a petri dish test kit click here. You will see more of our mold testing consultants information on that topic.

Trichoderma mold growing in a petri dish. When this mold is found, it is a possible indicator of water damage.

Three colonies of Penicillium mold growing in a petri dish. Penicillium is one of the most common molds found in home test kits. However, it is not typically this beautiful when observed in home mold test kits. The red and clear objects are liquid droplets of water and waste products released by the colonies. It’s not just the spores that make people sick. Sometimes the mold’s waste products make people sick.
Images of Petri Dish Mold With Identification.
(Top View of Dish)
A mold inspection client of mine purchased this home mold test kit and used it in a bathroom. I took the petri dish home and analyzed it’s contents under the microscope so I could share it with you here on my website.
The elongated pinkish creamy or milky colony in the exact center of the petri dish is yeast. Yeast typically has this smooth, wet, creamy, milky, pinkish, appearance. It is common to find
a few of these colonies growing in these mold test kits.
To the right the velvety dark grey colonies are Cladosporium mold. These colonies are extremely common in petri dishes, expect to find it in your test kit. They start out white and later turn grey or black.
To the bottom right the fuzzy white cotton like colonies are not producing spores yet. They appeared to be Cladosporium and Pen Asp mold that had not produced spores yet. Once they produce spores ID will be easier.
These are very common and in almost every mold test kit.
I was not able to identify the small bright orange colony on the bottom left.
The large colony on the top left that looks like black sand is Aspergillus niger. This Aspergillus niger mold may indicate a leak because it loves lots of water.
And to the top right of the Aspergillus niger is a small wrinkly greenish gray colony of Pen Asp. As it matures it will produce more spores and thus may become darker green.
Always have a lab ID your home mold test kits as it takes lots of training and experience to ID molds properly.
Images of Petri Dish Mold With Identification.
(Reverse or Bottom View of Dish.)
This is the bottom side or reverse side of the above previously mentioned petri dish. I turned it over because you don’t just look at the top of a mold colony to identify it in a petri dish. You must also look at the bottom or reverse side.
he elongated creamy white colony in the exact center of the petri dish is yeast. Yeast typically has this creamy off white appearance in the reverse view. It is common to find a few of these colonies growing in home test kits.
To the left the dark black colonies are the bottom view of Cladosporium mold. The bottom view of Cladosporium is very black. It can also be olive brown to blackish brown on the reverse. These colonies are extremely common in petri dishes, expect to find it in your test kit.
To the bottom right the few white colonies appeared to be Cladosporium and Pen Asp mold that had not produced spores yet. Once they produce spores ID will be easier. These are very common and in almost every mold test kit.
The large colony on the top right looks a little wrinkly on the bottom. It is interesting that it looks like black sand on the top view, but on this reverse view it is a completely different off white color. It typically has a whitish or pale yellow color on the reverse. This mold is Aspergillus niger. This Aspergillus niger mold may indicate a leak because it loves lots of water.
And to the top right of the Aspergillus niger is a small wrinkly white colony of Pen Asp. Note that Pen Asp looks completely different on the white bottom than on its greenish top.
There are hundreds of species of Pen Asp mold. They vary in color and appearance in Petri dishes. However, many start off white and then later have a greenish color on the top and a white, off white, or yellowish color on the bottom.
Molds do not produce spores on the bottom, so they often have a completely different color on the bottom.
I have training and experience doing microscopic fungal identification. I also used the book titled Identifying Filamentous Fungus A Clinical Laboratory Handbook as a referenced for these identifications.
Always have a lab ID your home mold test kits as it takes lots of training and experience to ID molds properly.
Petri Dish Test Kits V.S. Mold Testing Companies.
1) Home mold test kits have many serious limitations when compared to qualified mold testing companies. These kits are very simple dishes, thus do not draw in a given amount of air for a given amount of time. Because of this there is no way of calculating the number of spores per given volume of air. With these kits you will not know if the spores that settled and grew are normal expected levels of spores found in every house, or if your levels are elevated.
2) Another drawback of mold testing kits when compared to home mold testing specialists is the fact that most are not designed to sample and grow Stachybotrys, AKA toxic black mold. This mold grows very slowly. By the time it is starting to germinate in the petri dish, the dish has likely already been disposed of by the lab analysts.
3) Since sampling was not conducted by a qualified mold testing company you will most likely have no idea about possible hidden mold. Petri dishes will likely not pick up spores if the mold is in a wall or in a floor. Even a trained and qualified mold testing consultant with years of experience is not guaranteed to find hidden mold. However, they will be more likely to find concealed problems if the evidence has not been intentionally hidden. For example, a mold inspector might not find hidden mold but they will likely find evidence of likely mold in the form of water damage on a floor or wall.
Most Importantly
4) In addition, because a professional home mold testing company was not consulted, you may not know why the mold grew. I cannot stress enough the importance of this. You will not know how to properly remove the mold. And you will not know how to correct the problem that started the mold growth.

Stock image of inspector. Not all mold testing companies are the same. Make sure your inspector is qualified.
Benefits of Mold Testing Companies.
You will benefit much more by obtaining the services of an experienced, trained, and properly certified mold testing company, Certified Indoor Environmental Consultant, or Certified Industrial Hygienist.
Clues and red flags may exist that sometimes signal that a mold problem or moisture condition exists. Such clues may go unnoticed by the homeowner with a home test kit.
Your mold testing company’s professional should know how to look for red flags. The testing consultant should give you a comprehensive inspection report which documents visual findings, environmental monitoring results, and interpretation of lab results. Furthermore, they will also provide the inspector’s conclusions, and recommendations on how to remove the mold problem.
Worth the Investment

When mold testing companies provide an inspection report, the report reflects the actual conditions in your property as interpreted by an actual inspector who knows your concerns and your property. They have spent hours inspecting your home. Test kits do not provide this level of property specific data and knowledge.
Mold inspections from qualified mold testing companies are worth the investment. Such services cost hundreds of dollars more than a test kit. Mold inspections generally take 2 to 3 hours. In addition, an inspector and the inspectors report will help you understand far more than a home test kit will.
Do you feel that the condition of your home and your health are worth the investment in a mold inspection?
Our mold testing service in South Florida can provide such services.
A Accredited Mold Inspection Service.
1-888-381-6651